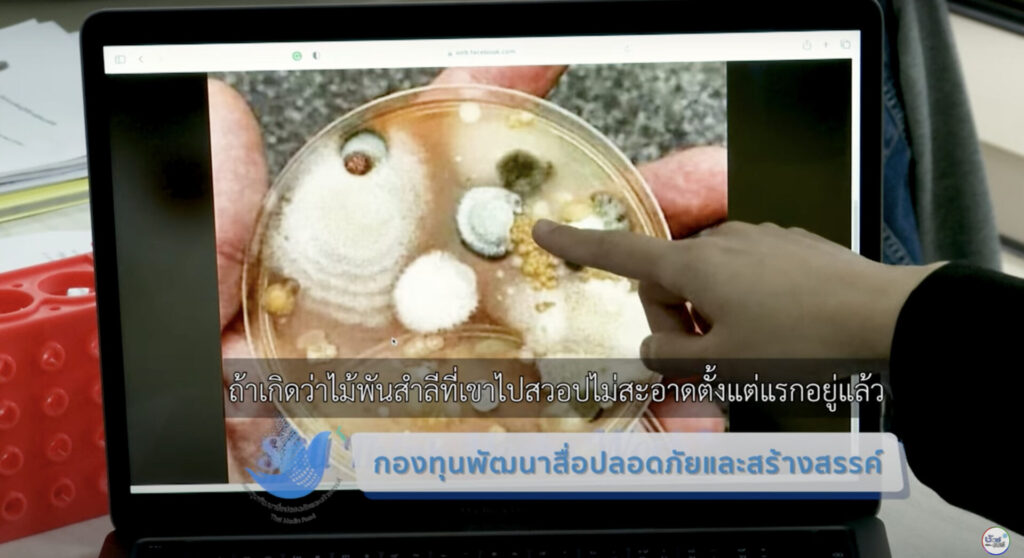

3 พฤษภาคม 2566 – จากกรณีที่มีการแชร์เกี่ยวกับวิธีการใช้หน้ากากอนามัยไว้มากมาย เช่น ห้ามใช้แอลกอฮอล์พ่นหน้ากากอนามัยเพราะจะทำให้เสื่อมประสิทธิภาพ หรือ หน้ากากผ้าที่เราใช้กันนั้นป้องกันโควิด-19 ไม่ได้ เรื่องไหนจริง เรื่องไหนเท็จ พบคำตอบได้ที่ชัวร์ก่อนแชร์ CHECK-LIST ร้อยเรียงเรื่องฮิต ติดอันดับกับชัวร์ก่อนแชร์

อันดับที่ 1 : มีวิธีใช้หน้ากากอนามัยหลายวิธี จริงหรือ ?
บนสังคมออนไลน์แชร์แนะนำวิธีใช้หน้ากากอนามัยที่ถูกต้อง โดยผู้ป่วยกับคนที่ไม่ป่วยจะต้องใช้สลับด้านกัน เรื่องนี้จริงหรือไม่ ?
ตรวจสอบข้อเท็จจริงกับ : พญ.จริยา แสงสัจจา ผู้อำนวยการสถาบันบำราศนราดูร
บทสรุป : ไม่จริง ไม่ควรแชร์ ❌
“การใส่หน้ากากอนามัยมีแบบเดียว คือใส่ให้ด้านที่มีสารเคลือบกันน้ำหรือด้านมัน ออกข้างนอกเสมอ และเมื่อสวมใส่ก็ควรจะกดพลาสติกให้แนบกับสันจมูกและใบหน้าของเราอยู่เสมอ”

อันดับที่ 2 : หน้ากากผ้าป้องกันโควิด-19 ไม่ได้ จริงหรือ ?
บนสังคมออนไลน์มีการแชร์ว่าหน้ากากผ้าอาจไม่สามารถป้องกันไวรัสโควิด-19 และการแพร่กระจายได้ เรื่องนี้จริงหรือไม่ ?
ตรวจสอบข้อเท็จจริงกับ : นพ.สุวรรณชัย วัฒนายิ่งเจริญชัย อธิบดีกรมอนามัย
บทสรุป : ไม่จริง ไม่ควรแชร์ ❌
“หน้ากากผ้าสามารถป้องกันไวรัสโควิด-19 ได้จริง การใช้หน้ากากผ้าอย่างน้อยก็เป็นการป้องกันที่ดีกว่าการไม่ได้สวมใส่หน้ากากชนิดใดเลย นอกจากนี้หน้ากากผ้ายังสามารถป้องกันเชื้อไวรัสโควิด-19 ที่ออกมากับสารคัดหลั่ง เช่น น้ำลาย น้ำมูก แต่สำหรับผู้ป่วยโควิดที่มีอาการไอ จาม ควรใช้หน้ากากอนามัยทางการแพทย์จะช่วยป้องกันเชื้อโรคกระจายออกไปได้มากกว่าหน้ากากแบบผ้า”
อันดับที่ 3 : ภาพแบคทีเรียในหน้ากากอนามัยที่ใส่ไป 20 นาที จริงหรือ ?
บนสังคมออนไลน์มีการแชร์ภาพจานเพาะเชื้อ บอกว่าเป็นแบคทีเรีย ที่นำมาจากการใช้สำลีป้ายในหน้ากากอนามัยที่คนสวมใส่เป็นเวลา 20 นาที เรื่องนี้จริงหรือไม่ ?
ตรวจสอบข้อเท็จจริงกับ : อ.พญ.ดร.กรวลี มีศิลปวิกกัย ภาควิชาจุลชีววิทยา คณะแพทยศาสตร์ จุฬาลงกรณ์มหาวิทยาลัย
บทสรุป : ไม่จริง ไม่ควรแชร์ ❌
“แม้จะพบเชื้อแบคทีเรียอยู่ในหน้ากากอนามัยที่เราใส่อยู่ก็จริง แต่เชื้อดังกล่าวเป็นเชื้อที่พบได้ในร่างกาย ไม่เป็นอันตรายต่อตัวเราแต่อย่างใด”

อันดับที่ 4 : ห้ามใช้แอลกอฮอล์พ่นหน้ากากอนามัย จริงหรือ ?
บนสังคมออนไลน์แชร์คลิปเตือนว่า ห้ามใช้แอลกอฮอล์พ่นฆ่าเชื้อหน้ากากอนามัยเด็ดขาด เนื่องจากแอลกอฮอล์จะละลายชั้นที่ช่วยป้องกันการซึมผ่านของน้ำและสารคัดหลั่ง เรื่องนี้จริงหรือไม่ ?
ตรวจสอบข้อเท็จจริงกับ : ศ.ดร.ธีรยุทธ์ วิไลวัลย์ ผอ.ศูนย์ความปลอดภัยอาชีวอนามัยและสิ่งแวดล้อม และหัวหน้าภาควิชาเคมี คณะวิทยาศาสตร์ จุฬาลงกรณ์มหาวิทยาลัย
บทสรุป : จริง แชร์ได้ ✅
“หน้ากากอนามัยทางการแพทย์จะมีสารเคลือบป้องกันของเหลวกระเด็นเข้ามา หรือซึมออกไป การใช้แอลกอฮอล์ฉีดลงบนหน้ากากอนามัย อาจจะทำให้ประสิทธิภาพในการป้องกันน้ำเสื่อมลงได้”

อันดับที่ 5 : หน้ากากที่ไม่มี VFE ไม่ป้องกันไวรัส จริงหรือ ?
บนสังคมออนไลน์แชร์เตือนผู้ใช้หน้ากากอนามัยว่า ระวัง! หน้ากากที่ไม่มีเครื่องหมาย VFE เพราะจะป้องกันไวรัสไม่ได้ เรื่องนี้จริงหรือไม่ ?
ตรวจสอบข้อเท็จจริงกับ : รศ.ดร.พานิช อินต๊ะ หัวหน้าหน่วยวิจัยสนามไฟฟ้าประยุกต์ในงานวิศวกรรม มหาวิทยาลัยเทคโนโลยีราชมงคลล้านนา
บทสรุป : ไม่จริง ไม่ควรแชร์ ❌
“หน้ากากที่มี BFE และ PFE สามารถป้องกันแบคทีเรียได้อยู่แล้ว โดยไม่ต้องมี VFE ที่เป็นการทดสอบเสริม อย่างไรก็ตามการเลือกซื้อหน้ากากที่ได้มาตรฐานต้องมี มอก. หรือ อย. กำกับ เป็นสิ่งสำคัญที่ควรคำนึงมากกว่า”
ตรวจสอบข้อเท็จจริงโดย : พีรพล อนุตรโสตถิ์, ณัฐวัฒน์ จิตรมั่น
เรียบเรียงโดย : ชยานิษฐ์ ผ่องใส
หากได้รับอะไรมา อย่าเพิ่งแชร์ต่อ ส่งมาตรวจสอบกับ “ศูนย์ชัวร์ก่อนแชร์”
LINE :: @SureAndShare หรือคลิก http://line.sure.guru
FB :: https://www.facebook.com/SureAndShare
YouTube :: https://www.youtube.com/@SureAndShare
Twitter :: https://www.twitter.com/SureAndShare
IG :: https://instagram.com/SureAndShare
Website :: http://www.ชัวร์ก่อนแชร์.com
TikTok :: https://www.tiktok.com/@sureandshare
สมัครรับฟรี ชัวร์ก่อนแชร์ Newsletter ส่งถึงกล่องอีเมลของคุณทุกสัปดาห์ :: https://i.sure.guru/sureandshareNewsletter














